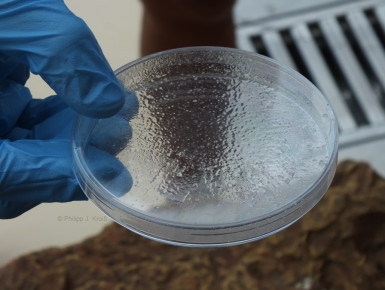

Unterricht
Eine zweite Säule der Show ist die Edukation. Es wird biologisches Grundwissen vermittelt (u.a. Echolokalisation, anatomische Begebenheiten) und auch erklärt, wie man gestrandeten Walen hilft.
Die Kanarischen Inseln sind ja durchaus mit vielen Walarten bedacht (laut Wissenschaftlern 30 Arten, wovon sieben Walarten (misticetos) sind und 23 Delfinarten (odontocetos)), die sich in den Gewässern um sie herum tummeln und da ist es nicht schlecht, wenn die Leute lernen, wie man gestrandeten Tieren hilft. In diesem Teil des Atlantiks initiierte und ermöglichte übrigens die Loro-Parque-Stiftung ein Schutzgebiet.
Direkte Berührung
Ebenfalls ein wichtiger Punkt in der Show ist, dass ein ausgewähltes Kind mit den Tieren in Berührung kommt. Diese Interaktion wird natürlich sehr gut betreut und ist weder für Mensch noch Delfin in irgendeiner Weise gefährlich. Wichtig ist dieser Showbestandteil wieder im Sinne des ersten Punktes, der weiter oben erwähnt wurde.
Delfine entscheiden selbst, ob sie teilnehmen
Grundsätzlich sind die Delfine außerhalb der Shows zusammen. Bevor das Programm beginnt, erhält jedes Tier die Möglichkeit, seinen Willen zu bekunden, ob es an der Präsentation teilnehmen möchte oder eben nicht.
Aber auch während der Show ist diese Unterscheidung nicht fest zementiert: Haben Tiere zwischendurch keine Lust mehr oder dann doch, wird flexibel reagiert und dem jeweiligen Wunsch entsprochen.
Auch die Teilnahme am Training ist völlig freiwillig. Die Trainer bieten den Tieren eine Trainingseinheit an und wenn die Delfine nicht wollen, dann wollen sie eben nicht – niemand zwingt sie zu irgendetwas. Ähnlich verhält es sich bei routinemäßigen Gesundheitsüberprüfungen.
Dass die Tiere allerdings nicht wollen, geschieht sehr selten. Grundsätzlich sind die Tiere enorm interessiert, verspielt und lieben die Interaktion mit den Trainern; Studien beweisen ja auch, dass Delfine beim Training positiv empfinden und Glückshormone ausschütten.
Positive Verstärkung
Wie jedes seriöse, wissenschaftlich geführte Delfinarium arbeitet auch der Loro Parque mit dem Prinzip der positiven Verstärkung.
Es ist das einzige System, das wirklich funktioniert und enorm gut erforscht und erprobt ist.
Es zeichnet sich dadurch aus, dass man den Tieren im Training keine negativen Stimuli gibt. Falsches Verhalten wird nicht negativ sanktioniert, sondern allein das gewollte, richtige Verhalten bei den Trainingssessions positiv bestärkt.
Jeden Tag Fisch in Restaurantqualität
Vier bis acht Kilo Fisch bekommt ein Großer Tümmler im Loro Parque am Tag. Davon unabhängig ist, ob das Tier an Shows oder Trainings partizipiert hat. Man achtet darauf, dass die Tiere zwischen 10.000 und 12.000 Kalorien bekommen, damit ihr Grund- und ihr Entwicklungsbedarf gut gedeckt sind.
Schaut man sich die Tiere genau an, sieht man den hervorragenden Zustand.
Alle 1,5 Monate bekommt der Park eine Lieferung von tiefgefrorenem Fisch aus nachhaltigem und umweltverträglichem Fischfang. Verfüttert werden Hering, Sprotte und Kapelan (auch: Lodde) in einer Qualität, wie man sie im Restaurant nicht besser bekommen würde.
Aber allein auf das Qualitätsversprechen verlässt man sich nicht. Es werden immer zwei Proben genommen: eine muss der Lieferant vorlegen und eine überprüft man im Park selbst.
Man überlässt hier rein gar nichts dem Zufall und sorgt dafür, dass die Tiere nur das Beste gefüttert bekommen.
Medical Training
Jeden Monat wird jedes Tier einmal komplett medizinisch bzw. prophylaktisch gecheckt: Dazu gehören Gewichtskontrolle, Ultraschall, Temperatur und eine Überprüfung von Augen, Ohren und Haut.
Das wird auf verschiedene Tage und Trainingseinheiten aufgeteilt und kann von Trainer und Tier überall im Beckensystem absolviert werden.
Bei Bedarf würden die Kontrollen natürlich engmaschiger, aber da alle Tiere sich momentan bester Gesundheit erfreuen, ist das gar nicht nötig.
Delfine sind frei vom Poxvirus
Ein Spezifikum der Population im Loro Parque ist, dass keines der Tiere für den Poxvirus positiv ist. Das findet man in der Wildbahn und in Menschenobhut sehr selten bei Delfingruppen.
Erkennbar ist der Virus an sogenannten „Tatoo“-Läsionen in der Haut, die den Tieren aber keinerlei Nachteil bieten. Weder in der Wildbahn noch in Menschenobhut beeinträchtigt es die Gesundheit der Tiere an sich.
Es lässt sich gut mit Herpes vergleichen: Nicht so hübsch, aber jetzt im Normalfall auch nicht wirklich gesundheitsbedrohlich – es ist also nicht tragisch, wenn Delfine das haben; viele Tausende haben es auf dem ganzen Erdball in sämtlichen Ozeanen. Nur im Loro Parque hat es eben kein Tier, was etwas Besonderes ist und schon durch unabhängige Experten bestätigt wurde. Also ein spannender Fakt für alle veterinärmedizinisch interessierten Delfinfreunde.
Hier geht es zur Seite 3.

Auf welche Studien wird sich in dem Absatz „Delfine entscheiden selbst, ob sie teilnehmen“ im letzten Satz bezogen?
U.a. https://www.cambridge.org/core/journals/animal-welfare/article/abs/cwell-the-development-of-a-welfare-assessment-index-for-captive-bottlenose-dolphins-tursiops-truncatus/2B6F13C12EBCF55412E85F02DD3EA4DC
Was die Freiwilligkeit bei der Teilnahme an den „Shows“ angeht:
Die Anlage in LoroParque ist so gebaut, dass die Delfine aus ihren (für Besucher normalerweise nicht zugänglichen*) Ruhebecken aktiv durch einen Tunnel (mit Luft über dem Wasserspiegel) unter der Tribüne in das Showbecken schwimmen müssen, um an der Präsentation teilzunehmen. Tun sie das nicht, werden sie auch nicht weiter behelligt.
Das führt dazu dass die Zahl der teilnehmenden Tiere sichtbar schwankt (3 – 7) je nach Wetter, Lust und Laune. Ebenso ist es nicht ungewöhnlich, dass während der Vorstellung noch ein Delfin dazu kommt, oder die Präsentation vorzeitig verlässt.
Hier noch von irgendeinem Zwang zu sprechen, ist schon reichlich weit hergeholt. – Obwohl: Die Delfintrainer stehen da schon ganz schön unter Druck, ihre Stars jedes mal aufs neue zu motivieren. ;-)
_____________________________________________
* wird nur bei den geführten „Behind the scenes“-Touren gezeigt
Danke für diesen interessanten Artikel! Besonders pfiffig finde ich die Idee, den Delfinen beizubringen, Fremdkörper im Delfinarium zu suchen und bei den Tierpflegern gege Fische einzutauschen. Das reduziert die Gefahr, dass versehentlich was verschluckt wird und gleichzeitig räumen die Tümmler damit selbst ihre „Wohnung“ auf.
Spannend auch die Sache mit den Glückshormonen, die bei den Tieren nachgewiesen wurden, wenn sie mit den Trainern spielen. Für mich ein Beweis dafür, dass die Tiere – wenn man es richtig macht – die Trainingseinheiten nicht als „Zwang“ oder „Stress“ empfinden, sondern richtig Spaß dran haben.